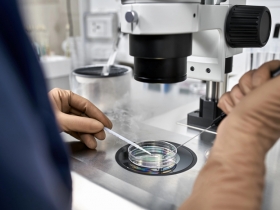
Why More Women Are Choosing to Freeze Their Eggs  Why More Women Are Choosing to Freeze Their Eggs

5 unsuccessful IVFs led us to Gynem Clinic. Both my husband and I are 46 yrs. old, and left it too late to start a family; assuming we had all the time in the world and that since we led an active heathy life, making babies would not be an issue.
We started trying approx. 8yrs ago, living in...